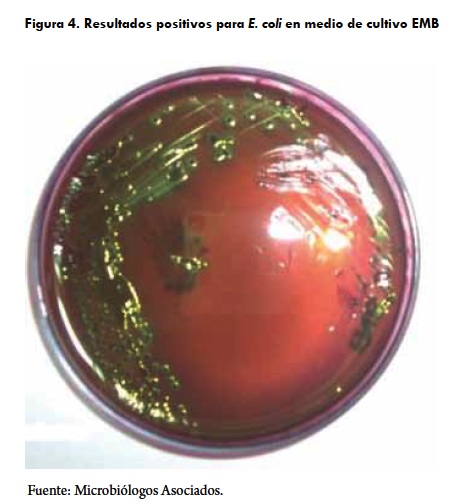

Services on Demand
Journal
Article
Indicators
-
Cited by SciELO -
Access statistics
Related links
-
Cited by Google -
Similars in
SciELO -
Similars in Google
Share
Revista de Medicina Veterinaria
Print version ISSN 0122-9354
Rev. Med. Vet. no.26 Bogotá July/Dec. 2013
Comparación de ácido láctico, ácido peroxiacético e hipoclorito de sodio en la desinfección de canales bovinas en un frigorífico de Bogotá, Colombia
Verónica Valencia Montero1 / Víctor Acero Plazas2
1 Médico veterinario, Universidad de La Salle, Bogotá, Colombia.
vvmvet@gmail.com
2 Médico veterinario, MSc (c) en Salud Pública, Universidad Nacional de Colombia, Bogotá, Colombia. Director ejecutivo, de la Asociación de Médicos Veterinarios de Colombia (AMEVEC).
sepulvic@hotmail.com
Recibido: 23 de julio del 2013. Aceptado: 19 de septiembre del 2013
Cómo citar este artículo: Valencia Montero V Acero Plazas V Comparación de ácido láctico, ácido peroxiacético e hipoclorito de sodio en la desinfección de canales bovinas en un frigorífico de Bogotá, Colombia. Rev Med Vet. 2013;(26):13-23.
Resumen
Los sistemas de desinfección desempeñan un papel importante en la disminución de peligros microbiológicos en canales bovinas. La desinfección allí es utilizada en las plantas de beneficio con el objeto de disminuir el número de microorganismos patógenos presentes en la superficie del producto. El objetivo de este estudio fue evaluar la eficacia de tres desinfectantes: ácido láctico (0,9 ± 2%), ácido peroxiacético (100 ± 20 ppm) e hipoclorito de sodio (100 ± 20 ppm) en la reducción de Escherichia coli y Salmonella spp. en la superficie de canales bovinas, dentro de las instalaciones de un frigorífico de la sabana de Bogotá. Se seleccionaron 78 canales bovinas visualmente contaminadas durante el proceso de faenado, ya fuera con materia fecal o con ingesta; se muestrearon antes e inmediatamente después de aplicado el desinfectante mediante aspersión con máquina dosificadora. En la reducción de E. coli no se encontraron diferencias significativas entre los tres tratamientos (p > 0,05). El ácido láctico, el ácido peroxiacético y el hipoclorito de sodio obtuvieron un promedio de reducción de E. coli de 1,05, 1,38 y 1,01 log10 UFC/cm2, respectivamente. De las muestras tomadas ninguna obtuvo resultados positivos para Salmonella spp. Teniendo en cuenta los resultados de eficacia, el bajo costo a concentraciones de 0,9 ± 2% y las ventajas de manipulación, se recomienda la implementación de ácido láctico como desinfectante de canales dentro de las instalaciones de frigoríficos de bovinos, y este tipo de prácticas se puede repetir en plantas de aves y porcinos.
Palabras clave: Escherichia coli, planta de beneficio, Salmonella spp., desinfección.
Comparison of Lactic Acid, Peracetic Acid and Sodium Hypochlorite in Disinfection of Bovine Carcasses at a Meat Processing Plant in Bogota, Colombia
Abstract
Disinfection systems play an important role in reducing microbiological hazards in cattle carcasses. Disinfection is used in processing plants to decrease the number of pathogenic microorganisms present in the surface of the product. This study evaluated the efficacy of three disinfectants: lactic acid (0.9 ± 2%), peroxyacetic acid (100 ± 20 ppm) and sodium hypochlorite (100 ± 20 ppm) in reducing Escherichia coli and Salmonella spp. in the surface of bovine carcasses within the premises of a meat processing plant in the savanna of Bogota. Seventy-eight (78) cattle carcasses thate were visually contaminated during the slaughtering process, either with fecal matter or through ingestion, were selected; they were sampled before and immediately after applying the disinfectant by spraying with dosing machine. No significant differences between the three treatments (p> 0.05) were found in the reduction of E. coli. Lactic acid, peracetic acid and sodium hypochlorite had an average reduction of E. coli of 1.05, 1.38 and 1.01 log10 UFC/cm2, respectively. None of the samples taken had positive results for Salmonella spp. Considering the results as to efficacy, low cost at 0.9 ± 2% concentrations and handling advantages, it is recommended to implement lactic acid as carcass disinfectant in bovine meat processing plant facilities; in addition, such practices can be replicated in pig and poultry plants.
Keywords: Escherichia coli, processing plant, Salmonella spp., disinfection.
Comparação de ácido láctico, ácido peracético e hipoclorito de sódio na desinfecção de canais bovinos em um frigorífico de Bogotá, na Colômbia
Resumo
Os sistemas de desinfecção desempenham um papel importante na diminuição de perigos microbiológicos em canais bovinos. A desinfecção é utilizada nas plantas de benefício, com a finalidade de diminuir o número de micro organismos patogênicos presentes na superfície do produto. Este estudo avaliou a eficácia de três desinfetantes: ácido láctico (0,9 ± 2%), ácido peracético (100 ± 20 ppm) e hipoclorito de sódio (100 ± 20 ppm) na redução de Escherichia coli e Salmonella spp. Na superfície de canais bovinos, dentro das instalações de um frigorífico da planície de Bogotá. Foram selecionados 78 canais bovinos visualmente contaminados durante o processo de limpeza, já fosse com fezes ou com ingestão; foram tomadas amostras antes e imediatamente depois de que fosse aplicado o desinfetante mediante aspersão com máquina de dosagem. Na redução de E. coli não se encontraram diferenças significativas entre os três tratamentos (p > 0,05). O ácido láctico, o ácido peracético e o hipoclorito de sódio obtiveram uma média de redução de E. coli de 1,05, 1,38 e 1,01 log10 UFC/cm2, respectivamente. Das amostras tomadas nenhuma obteve resultados positivos para Salmonella spp. Considerando os resultados de eficácia, o baixo custo a concentrações de 0,9 ± 2% e as vantagens de manipulação, recomenda-se a implementação de ácido láctico como desinfetante de canais dentro das instalações de frigoríficos de bovinos, e este tipo de práticas se podem replicar em galpões de aves e currais suínos.
Palavras chave: Escherichia coli, planta de benefício, Salmonella spp., desinfecção.
INTRODUCCIÓN
El propósito de este escrito es describir la importancia de las estrategias que existen para disminuir la contaminación en canales procesadas en una planta de sacrificio. Los sistemas de desinfección desempeñan un papel importante en la disminución de peligros microbiológicos patógenos presentes en la superficie de canales. La contaminación de las canales que ocurre durante la faena es indeseable e inevitable; la fuente primaria de contaminación proviene del mismo animal, en el que pueden habitar bacterias patógenas como E. coli, Salmonella y Listeria monocytogenes, que son conocidas como una amenaza para la salud del consumidor (1).
La contaminación de canales es altamente variable en extensión y lugar. La mayoría ocurre inmediatamente después del retiro de la piel en la superficie externa de la canal (figura 1), pero la parte interna del músculo permanece esencialmente estéril (2). La contaminación superficial es originada por la piel del animal, ya que la canal se expone al pelo acumulado con polvo, mugre y materia fecal (3). Otras fuentes son contenido gastrointestinal, equipos, personal, utensilios y ambiente de trabajo (agua y aire) (4), teniendo como consecuencia la necesidad de implementar procedimientos higiénicos efectivos dentro de las plantas de beneficio durante la faena (2).
Una estrategia utilizada es el corte con cuchillo o expurgo —como se le denomina en la planta—, que es un método tradicional de descontaminación de canales donde se realiza el retiro de la parte que contiene contaminación visible; sin embargo, las bacterias de origen fecal no están confinadas a estas áreas y se aumenta la posibilidad de diseminar patógenos con los cuchillos, además de que exige mayor manipulación de la canal por operarios e inspectores (5).
En este estudio se evaluaron tres métodos de desinfección de canales: ácido láctico (AL), ácido peroxiacético (AP) e hipoclorito de sodio (HS), para determinar la eficacia en la eliminación de microorganismos patógenos y su viabilidad económica.
En el último censo realizado por el Instituto Nacional de Vigilancia de Medicamentos y Alimentos (Invima), en 2007, se mencionó que existían 1507 plantas de beneficio de las especies bovinas y bufalinas, de las cuales 558 plantas regulares y 74 plantas de régimen especial presentaron el plan gradual de cumplimiento, es decir, aproximadamente la mitad estaría dispuesta a cumplir con los requisitos sanitarios y de inocuidad del Decreto 1500 de 2007, que regía en ese momento. En esa norma se obliga a todas las plantas de beneficio a mejorar la calidad microbiológica regulando los límites máximos permitidos para E. coli biotipo I y Salmonella spp. Por esta normativa surge la necesidad de implementar sistemas de eliminación de este tipo de microorganismos, por lo que se recomienda la desinfección como herramienta complementaria en sistemas de gestión de inocuidad (6).
El objetivo de este estudio fue brindar una herramienta para contribuir con la seguridad alimentaria y la disminución de las enfermedades originadas por alimentos, como complemento a la aplicación de las buenas prácticas de manufactura que deben estar implementadas antes y durante el proceso de obtención del producto final (7).
MATERIALES Y MÉTODOS
El muestreo se realizó dentro de las instalaciones de un frigorífico de Bogotá (Colombia), con canales bovinas dentro del proceso de faenado. La frecuencia de muestreo fue de siete días, alternando que fueran diferentes durante cada semana. Los tratamientos utilizados fueron ácido láctico (AL) a 0,5-0,9%, método aprobado en Estados Unidos y en Australia por el U. S. Department of Agriculture (USDA) y por el Food Safety and Inspection Service (FSIS) desde el 2004; ácido peroxiacético (AP), aprobado por el FSIS para la desinfección de canales desde el 2003, e hipoclorito de sodio (HS), aceptado como método de desinfección de canales por el FSIS en 1995. El número de muestras fue de 78 canales en total: 26 para AL, 26 para AP y 26 para HS. Para la aplicación de ácido láctico se utilizó una máquina dosificadora marca CHAD® y para los otros dos tratamientos se utilizó un aspersor de espalda manual. Para la manipulación de los desinfectantes se tuvieron en cuenta las recomendaciones de la ficha de seguridad de cada producto. En este estudio se trabajó con concentraciones bajas, dado a que se tuvieron en cuenta aspectos económicos y posibles cambios sensoriales en las canales, tal como lo menciona Harris (8).
Para el muestreo se seleccionaron canales bovinas visualmente contaminadas durante el proceso de faenado, ya fuera con materia fecal o con contenido gastrointestinal (figura 2). Después se aplicó el tratamiento durante aproximadamente veinte segundos (figura 3). Posteriormente la misma canal fue muestreada mediante frotis con esponja en el pecho, el brazo o la espalda. Las muestras fueron identificadas y transportadas al laboratorio para su análisis microbiológico.
Para la determinación de Salmonella spp. se incubaron las muestras por un periodo de 24 a 48 horas a 35 °C en Agar Xilosa, Lisina, Desoxicolato (XLD) y Hektoen; y para la determinación de E. coli se utilizó la técnica por recuento en placa en Agar Eosina Azul de Metileno (EMB) (figura 3). El periodo de incubación fue de 18 a 24 horas a una temperatura de 35 °C a 37 °C, según lo descrito por Collins (9).
Para el análisis de los resultados, los datos cuantitativos de los recuentos bacterianos fueron transformados de UFC/cm2 a Log (UFC/cm2). La determinación de la eficacia se realizó mediante la fórmula: Eficacia de la reducción = (log10 UFC/cm2 antes del tratamiento) - (log10 UFC/cm2 después del tratamiento), según lo descrito por Graves (10). La comparación de la eficacia en la reducción de los tres tratamientos se determinó aplicando un análisis de varianza (Anova); se consideraron significativos los efectos a p < 0,05. Para el tratamiento y análisis de datos se utilizó el programa SPSS, versión 17 (2008). Finalmente, se calcularon los costos de cada tratamiento para determinar cuál era el más económico para implementar en la planta de beneficio.
RESULTADOS
Para Salmonella spp., de las 26 muestras antes de ser aplicado cualquiera de los 3 desinfectantes, no se obtuvieron resultados positivos, por lo que no fue posible determinar la eficiencia de desinfección. Los resultados de E. coli mostraron colonias en el medio EMB de centro grande, de color oscuro y verdes brillantes (figura 4).
Los resultados expresados log10 UFC/cm2 antes de aplicado el desinfectante para AL, AP y HS fueron 1,12, 1,64 y 1,23 respectivamente. Después de aplicado el desinfectante los resultados para AL, AP y HS fueron 0,07, 0,26 y 0,21 respectivamente. En la figura 5, por medio de diagramas de cajas, se muestra el intervalo de confianza que toma hacia arriba y hacia abajo la reducción logarítmica de los tres desinfectantes.
Se realizó la comparación entre los tres desinfectantes por medio del Anova, con una significancia del 0,074 (p < 0,05). Se demuestra que no hay diferencia entre los tratamientos y que los tres son eficaces en la desinfección de canales bovinas. Adicionalmente se realizó el test Kruskal-Wallis y se determinó que no existen diferencias entre los tratamientos, pues se obtuvo una significancia de 0,073 (p < 0,05). La distribución de las variables no es normal.
En cuanto a los resultados para Salmonella se determinó que la incidencia en canales bovinas dentro de la planta de beneficio es del 0%, debido a que ninguna de las 78 muestras predesinfección obtuvo resultados positivos, por lo que no fue posible determinar la efectividad de los desinfectantes frente a este agente bacteriano.
Durante la fase experimental se manejaron el ácido láctico, el ácido peroxiacético y el hipoclorito de sodio. En la tabla 1 se resumen las ventajas y desventajas que tienen estos desinfectantes. La ventaja que se destaca para los tres es la facilidad de aplicación por medio de la aspersión sobre la canal; como desventaja general está la falta de capacitación de los trabajadores en cuanto a las Buenas Prácticas de Manufactura (BPM).
De igual manera, en el análisis de costo de los tratamientos aplicados, donde se utilizó una bomba aspersora de espalda, que es fácil de utilizar, se ahorraron costos en instalación de maquinaria, de adecuación de infraestructura y de mantenimiento; sin embargo, se requiere un operario que realice la aspersión. Para la aspersión de ácido láctico se utilizó la máquina aspersora instalada previamente dentro del frigorífico. En este caso se monitorea la presión y el funcionamiento de las boquillas con el fin de asegurar una aspersión uniforme.
En la tabla 2 se muestra el análisis de costos de los productos utilizados en este estudio. El hipoclorito de sodio es el que presenta menor costo por su baja dilución y precio de presentación; el ácido láctico es el segundo menor costo, con treinta pesos por litro. El ácido peroxiacético es el más costoso, pero no significa que no sea viable económicamente, ya que 48,4 pesos por litro no es un precio alto para un desinfectante efectivo.
DISCUSIÓN
En primer lugar, el control de las buenas prácticas de manufactura y de otros procesos no es suficiente en la disminución de patógenos entéricos; por lo tanto; se propone la utilización de sistemas de desinfección como medios para la eliminación o reducción de aquellos (11). Dentro de los aspectos importantes que tiene la producción de un alimento inocuo están el crear confianza al consumidor y la posibilidad de acceder a mercados extranjeros. La presencia de microorganismos patógenos en alimentos es uno de los intereses de la salud pública, debido a su incremento en frecuencia, la población vulnerable y el impacto socioeconómico (12).
La aplicación de desinfectantes ha sido extensamente estudiada en la reducción de bacterias en la superficie de canales. Muchos de estos sistemas han probado ser efectivos en el mejoramiento microbiológico y la calidad de las canales. En este estudio se utilizaron tres desinfectantes bajo condiciones del proceso de faenado, los cuales redujeron a niveles bajos o nulos la contaminación natural en la superficie de canales bovinas de E. coli.
La contaminación visual en la superficie de la canal debe ser retirada por medio de cortes antes del lavado y refrigeración. Esta práctica se ha visto implementada con éxito como procedimiento regular por el Departamento de Agricultura de los Estados Unidos en ese país (13). Por desgracia no interviene parte de la canal que visualmente no está contaminada, evitando la remoción de bacterias presentes; además, existe la posibilidad de transportar contaminación a otras áreas donde inicialmente no había (14). Castillo y cols. (15) compararon lavado con agua, corte con cuchillo con agua caliente y ácido láctico (2%, 55 °C) y concluyó que la reducción logarítmica es mayor cuando se combinaba el corte con cuchillo y algún sistema de desinfección (ácido láctico [2%] o agua caliente [95 °C]) para enterobacterias, bacterias mesofílicas aeróbicas, coliformes totales y E. coli. Todas las canales, presenten o no contaminación visual, deben ser aspersadas con un desinfectante. Castillo y cols. (15) compararon la aspiradora de vapor combinada con agua caliente (95 °C) y ácido láctico (2%, 55 °C), y como resultado comprobó que la aspiradora de vapor, utilizada para la terminación de las canales, por sí misma, no reduce los niveles como los que se obtuvieron con agua caliente y ácido láctico. Los tratamientos combinados redujeron enterobacterias, bacterias aeróbicas, coliformes totales y E. coli. hasta niveles de 1,0 log10 UFC/cm2.
Dentro de los estudios que demuestran la eficacia de estos desinfectantes, Castelo (16) comprueba, con cortes de cerdo, la efectividad del ácido láctico al 2% durante 75 segundos a una temperatura de 15 °C, disminuyendo las UFC de E. coli a niveles bajos de 0,11 UFC log. Castillo y cols. (15) y Hardin y cols. (17) comprueban que el ácido láctico al 2% en carcasas bovinas reduce coliformes totales y E. coli a niveles aceptables; sin embargo, en este estudio se obtuvieron los mismos resultados utilizando una concentración baja, ayudando a minimizar los cambios sobre la canal y el consumo del producto por litro, y reduciendo costos.
El uso del ácido peroxiacético a 200 ppm ha comprobado ser efectivo por Ransom y cols. (18), quienes obtuvieron resultados similares con 1,4 log10 UFC/cm2 en 30 segundos utilizando el método de inmersión en piezas de carne. Por otro lado, King y cols. (19) obtuvieron por aspersión una reducción de 0,7 log10 UFC/cm2 y Ellebracht y cols. (20) consiguieron reducciones de 0,6 log UFC/cm2 para E. coli en carcasas. Estos resultados concuerdan con lo obtenido en este estudio debido a que en esta investigación se utilizó el método de aspersión, con una duración de 20±5 segundos, y se obtuvieron resultados similares a los de inmersión. Esto comprobó que es un método fácil de implementar, con buenos resultados microbiológicos y de fácil acceso.
El hipoclorito de sodio redujo las bacterias presentes hasta 0,21 log UFC/cm2 con una eficacia de 1,01 log UFC/cm2. Cutter y Siragusa (21) reportan que el cloro no tiene una efectividad mayor a 1,3 log UFC/cm2 por la inactivación que tiene con la materia orgánica y debido a componentes nitrogenados asociados con carne roja. En cambio, Edwards y cols. (7) demuestran una efectividad de hasta los 2 log UFC/cm2 en canales bovinas. Las desventajas que presenta el hipoclorito de sodio hacen que los otros dos desinfectantes sean más factibles y confiables en la implementación dentro de plantas de beneficio, aunque gracias a su bajo costo se convierte en una alternativa para la desinfección de canales.
Las reducciones logarítmicas de agentes microbiológicos varían entre los diferentes estudios y métodos probados, ya que depende de la inoculación o el grado de contaminación inicial que se encuentre en la superficie de las canales. Esto favorece a obtener datos significativos y amplias numeraciones logarítmicas (22).
La contaminación de Salmonella se puede presentar desde la finca, en el proceso de sacrifico y faenado, durante la comercialización o en el momento de preparación de este tipo de alimentos en hogares y restaurantes. En el presente estudio ninguna canal bovina presentó Salmonella spp. Resultados similares se obtuvieron en Guatemala bajo una metodología similar, donde se recolectaron 300 muestras de pollo, cerdo y res, de las cuales tres fueron positivas a Salmonella procedentes de la carne de pollo (23). Investigaciones anteriores, como la realizada por Korsak y cols. (24) en Bélgica, también encontraron una baja prevalencia de Salmonella en 240 canales bovinas. Resultados similares a los obtenidos por Castro y cols. (25), quienes reportaron la presencia en un 11% en canales bovinas en un matadero ubicado en México. Yánez y cols. (26), en Montería, Córdoba, obtuvieron un caso positivo en 55 canales bovinas (1,8%).
CONCLUSIONES
Las prácticas de desinfección en canales bovinas deben ir en conjunto con procedimientos operativos estandarizados de sanitización (POES), con las buenas prácticas de manufactura y con supervisión. La desinfección de canales presenta una oportunidad en la reducción de microorganismos patógenos dando cumplimiento a la legislación y parámetros internos de la organización, prolongación de la vida media de la canal e inocuidad alimentaria.
La aplicación de los desinfectantes por medio del aspersor de espalda presenta una alternativa económica para la reducción de patógenos; se recomienda su utilización en plantas de beneficio y plantas procesadoras de alimentos para extender la vida de las canales, garantizar la inocuidad alimentaria y la salud pública.
Antes de implementar algún sistema de desinfección se debe asegurar que este no produzca ningún efecto sobre las características organolépticas de las canales o efectos adversos en la salud de los consumidores. Después debe ser probado para asegurar su funcionamiento bajo las condiciones de procesos de cada planta de beneficio o procesadora de alimento.
AGRADECIMIENTOS
A Frigoríficos Ble, por la colaboración en la toma de muestras. A Microbiólogos Asociados, por su procesamiento.
REFERENCIAS
1. Triveldi S, Reynolds AE, Chen J. Use of a commercial household steam cleaning system to decontaminate beef and hog carcasses processed by four small or very small meat processing plants in Georgia. J Food Prot. 2007;70(3):635-640. [ Links ]
2. Dorsa W, Cutter C, Siragusa G. Effect of steamvacuuming and hot water spray wash on the microflora of refrigerate beef carcass surface tissue inoculated with Escherichia coli O157:H7, Listeria innocua, and Clostridium sporogenes. J Food Prot. 1997;60(2):114-119. [ Links ]
3. Tinney KS, Miller MF, Ramsey CB, Thompson LD, Carr MA. Reduction of microorganisms on beef surfaces with electricity and acetic acid. J Food Prot. 1997;60(6):625-628. [ Links ]
4. Nutsch A, Phebus R, Reiman J, Shafer D, Leising J, Kastner C. Evaluation of steam pasteurization process in a commercial beef processing facility. J Food Prot. 1997;60(5):485-492. [ Links ]
5. Hardin MD, Acuff GR, Lucia LM, Oman JS, Savell JW. Comparison of methods for decontamination from beef carcass surfaces. J Food Prot. 1997;58(4):368-374. [ Links ]
6. Edwards JR, Fung D. Prevention and decontamination of escherichia coli o157:h7 on raw beef carcasses in commercial beef abattoirs. J Rapid Methods Autom Microbiol. 2006;14(1):1-95. [ Links ]
7. Sofos JN, Belk K E, Smith GC. Processes to reduce contamination with pathogenic microorganisms in meat. Proc. 45th Intl. Documento procedente de Congress of Meat Sci. and Tech.; 1999, ago 1-6, Yokohama, Japan. [ Links ]
8. Harris K, Miller MF, Loneragan GH, Brashears MM. Validation of the use of organic acids and acidified sodium chlorine to reduce Escherichia coli O157 and Salmonella typhimurium in beef trim and ground beef in simulated processing environment. J Food Prot. 2006;69(8):1802-1807. [ Links ]
9. Collins CH, Lyne P. Métodos Microbiológicos. España: Acribia S.A.; 2007. [ Links ]
10. Graves D, Sofos JN, Schmidt GR, Smith GC. Decontamination of Inoculated Beef with Sequential Spraying Treatments. J Food Sci. 1998;63(5):1-4. [ Links ]
11. Smulders FJ, Greer GG. Integrating microbial decontamination with organic acids in HACCP programmes for muscle foods: Prospects and controversies. Int J Food Microbiol. 1998;44(3):149-169. [ Links ]
12. González T, Rojas R. Enfermedades transmitidas por alimentos y PCR: prevención y diagnóstico. Salud Pública Mex. 2005;47(5):388-90. [ Links ]
13. United States Department of Agriculture (USDA). National Advisory Committee on Microbiological Criteria for Foods. Report on Generic HACCP for Raw Beef. Food Microbiol. 1994;10:449-488. [ Links ]
14. Cliver D. Microbial decontamination, food safety, and antimicrobial interventions [internet]. 2007 [citado 2013 jun 14]. Disponible en: http://www.cdfa.ca.gov/ahfss/Animal_Health/PHR250/2007/25007Antimic.pdf [ Links ]
15. Castillo A, Lucia LM, Goodson KJ, Savell JW, Acuff GR. Comparison of water wash, trimming, and combinated hot water and lactic acid treatments for reducing bacteria of fecal origin on beef carcasses. J Food Prot. 1998;61(7):823-828. [ Links ]
16. Castelo MM, Kang DH, Siragusa GR, Koohmaraie M, Berry ED. Evaluation of combination treatment process for the microbial decontamination of pork trim. J Food Prot. 2001;64(3):335-342. [ Links ]
17. Hardin MD, Acuff GR, Lucia LM, Oman JS, Savell JW. Comparison of methods for decontamination from beef carcass surfaces. J Food Prot. 1995;58(4):368-374. [ Links ]
18. Ransom JR, Belk KE, Sofos JN, Stopforth JD, Scanga JA, Smith GC. Comparison of intervention technologies for reducing Escherichia coli O157:H7 on beef cuts and trimmings. Food Prot Trends. 2003;23(1):24-34. [ Links ]
19. King DA, Lucia LM, Castillo A, Acuff GR, Harris KB, Savell JW. Evaluation of peroxyacetic acid as a post-chilling intervention for control of Escherichia coli O157:H7 and Salmonella typhimurium on beef carcass surfaces. Meat Sci. 2005;69(3):401-407. [ Links ]
20. Ellebracht JW, King DA, Castillo A, Lucia LM, Acuff GR, Harris KB, Savell JW. Evaluation of peroxyacetic acid as a potential pre-griding treatment for control of Escherichia coli O157:H7 and Salmonella typhimurium on beef trimmings. Meat Sci. 2005;70(1):197-203. [ Links ]
21. Cutter CN, Siragusa GR. Application of chlorine to reduce populations of Escherichia coli on beef. Journal of Food Safety. 1995;15(1):67-75. [ Links ]
22. Buenge D, Ingham S. Small plants intervention treatments to reduce bacteria on beef carcasses at slaughter [internet]. University of Wisconsin; 2003 [s.f.]. Disponible en: http://www.aamp.com/foodsafety/documents/BeefCarcassInterventionMethods.pdf [ Links ]
23. Celada MA. Prevalencia de Salmonella spp. en cultivos de muestra de carne derivada de animales de destase en el departamento de Guatemala [tesis especialización]. Guatemala: Universidad de Francisco Marroquín, Facultad de Medicina; 2004. [ Links ]
24. Korsak N, Daube G, Ghafir Y, Chahed A, Jolly S, Vindevogel H. An efficient sampling technique used to detect foodborne pathogens on pork and beef carcasses in nine Belgian abattoirs. J Food Prot. 1998;61(5):535-41. [ Links ]
25. Castro RJ, Hernández SJ, Román GA, Santos LE, Sánchez OI, Zúñiga EA. Condiciones microbiológicas en el proceso de sacrificio en un rastro municipal del estado de Hidalgo, México. Veterinaria México. 2007;38(2):187-95. [ Links ]
26. Yánez E, Máttar S, Durango A. Determinación de Salmonella spp. por PCR en tiempo real y método convencional en canales de bovinos y en alimentos de la vía pública de Montería, Córdoba. Infectio. 1998;12(4):246-254. [ Links ]